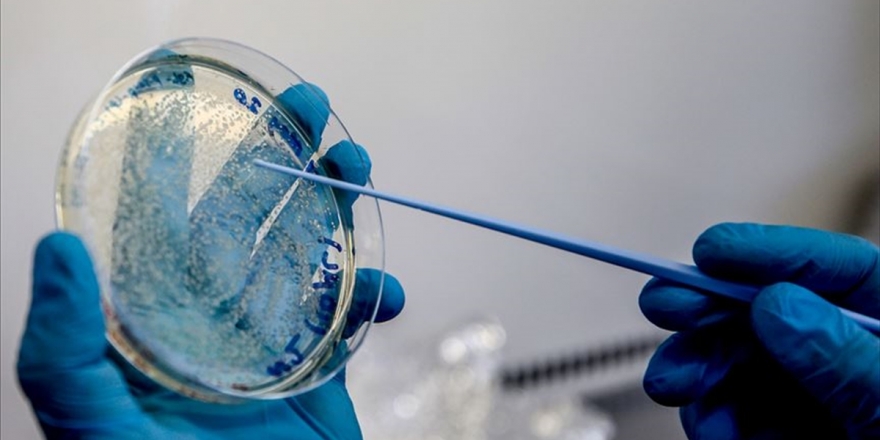

Reuters: Libya’daki Sirte planı nedeniyle Lavrov İstanbul ziyaretini erteledi
Rusya ağırlıklı olarak UMH’ye karşı silahlı mücadeleye giren Halife Hafter komutasındaki Libya Ulusal Ordusu’na (LUO) destek veriyor.
Rusya Dışişleri Bakanı Sergey Lavrov’un hafta sonu planladığı ve Türk yetkililerle görüşmek için yapacağı İstanbul ziyaretini ertelemesinde en önemli nedeninin, Ankara’nın desteklediği Libya Ulusal Mutabakat Hükümeti (UMH) güçlerinin Sirte’yi geri almak için hazırlandığı harekat olduğu belirtildi.
UMH Başbakanı Feyiz es Serrac’a bağlı güçler son haftalarda Türkiye’nin desteğiyle üst üste kritik bölgeleri ele geçirirken, stratejik olarak önemli bir pozisyonda bulunan Sirte için yaklaşık bir haftadır hazırlık yapıldığı belirtiliyor.
Reuters’a bilgi veren Ankara’ya yakın bir yetkili şöyle konuştu: “Lavrov’un gelmesi üzerinde çalışılan konularda teknik heyetin tam bir mutabakat sağlayamamasının etkisi oldu. Ama şu anda arka planda görüşmeler devam ediyor. İki bakanın bir araya gelip bir mutabakat sağlamasının yolu açılmaya çalışılıyor. Ancak o aşamaya gelinemedi. Görüşmenin ertelenmesindeki en önemli nedenlerden biri Sirte’nin geri alınmasına yönelik hazırlık.”
Sirte, UMH kontrolündeki Trablus ile Hafter’in kontrol ettiği Bingazi arasında bulunuyor ve Libya’nın başlıca enerji ihracat terminallerine en yakın şehri. Hafter’e bağlı güçler ocak ayında Sirte’yi ele geçirdi, ancak son haftalardaki kazanımları sonrasında UMH, geçen hafta şehre doğru ilerlemeye başladı. Sirte’ye yaklaşan UMH güçleri, yoğun hava saldırıları sonucunda bölgeden geri itildi.
Öte yandan Dışişleri Bakanı Mevlüt Çavuşoğlu İranlı mevkidaşı Cevad Zarif ile düzenlenen ortak basın toplantısında (Rusya ile görüşmenin) kriz çıktığı için ertelendiği şeklindeki değerlendirmelerin doğru olmadığını söyledi.
Yetkili: Sirte hedef olarak öne çıkmıştı
Aynı yetkili, Türkiye ve Rusya arasında bazı alanlarda farklılıklar olduğunun altını çizerek şöyle konuştu: “Bunlar Libya ve Suriye olarak öne çıkıyor. Şu anda Libya’da Saraç bölgede kendi gücünü ortaya koydu ve ilerliyor. Lavrov’un ziyaretinin ertelenmesinden temel konulardan biri Sirte’ye yönelik operasyon planı. Serrac hükümetinin ilerlemesi sırasında zaten belli yerler alınınca Sirte hedef olarak öne çıkmıştı.”
Yetkili şöyle devam etti: “Sonuçta darbe yapmaya çalışan ve iç savaşı getirenlerle mücadele edilmesi çok doğal. Rusya’nın bundan çok rahatsız olması gerekmiyor; çünkü Rusya zaten resmi olarak da orada Rus askeri olmadığını söyledi. Wagner Grubu’nun askerleri var ama onlarla Rusya’nın doğrudan bağlantısı olmadığını da açıkladı. O nedenle Rusya açısından bir sorun teşkil etmemeli. Şu anda Libya’da ateşkes çağrıları var ama kimse uymuyor. Orada sorunun bir an önce çözüme kavuşturulması gerekli.”

Türkçe karakter kullanılmayan ve büyük harflerle yazılmış yorumlar onaylanmamaktadır.